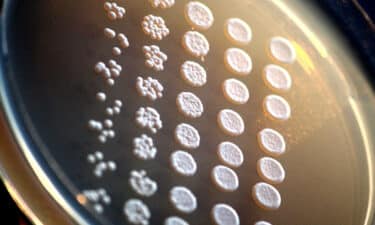
Beta Glukan: Bağışıklık Sistemi Güçlendirici ve Kanser Koruyucu

beta glukan
- Haz- 2018 -21 HaziranBeslenme

Beta Glukan: Bağışıklık Sistemi Güçlendirici ve Kanser Koruyucu
Kanser (ya da herhangi bir hastalık), sağlıklı bir bağışıklık sistemi olan bir kişide görülmez. Kansere karşı mücadelede sağlıklı bir bağışıklık…
Devamını Oku »